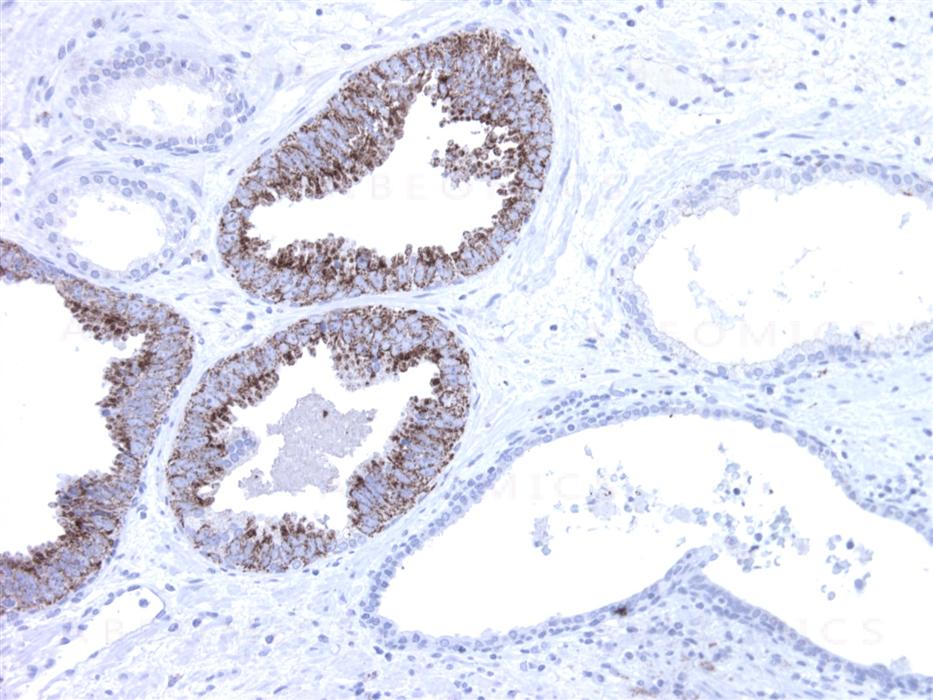

Mouse Monoclonal Antibody to AMACR(Clone :BS2) (Discontinued)
Figure-1: Prostate section has been stained using AMACR antibody (Clone: BS2) with 1:200 dilution. Neoplastic cells have strong granular staining. Note glands without neoplastic cells.
Roll over image to zoom in

Shipping Info:
For estimated delivery dates, please contact us at [email protected]
Amount : | 0.5 ml |
Isotype : | Mouse IgG2b |
Content : | TRIS with 0.03% sodium azide, pH7.2 |
Storage condition : | Store at 4°C |
AMACR (alpha-methylacyl-CoA racemase) has been recently described as prostate cancer-specific gene that encodes a protein involved in the beta-oxidation of branched chain fatty acids. Expression of AMACR protein is found in prostatic adenocarcinoma but not in benign prostatic tissue. It stains premalignant lesions of prostate: high-grade prostatic intraepithelial neoplasia (PIN) and atypical adenomatous hyperplasia. AMACR can be used as a positive marker for PIN. Defects in AMACR are the cause of congenital bile acid synthesis defect type 4 (CBAS4); also known as cholestasis, intrahepatic, with defective conversion of trihydroxycoprostanic acid to cholic acid or trihydroxycoprostanic acid in bile. Clinical features include neonatal jaundice, intrahepatic cholestasis, bile duct deficiency and absence of cholic acid from bile.
Immunohistochemical Analysis :-1:200
For Research Use Only. Not for use in diagnostic/therapeutics procedures.
Subcellular location: | Peroxisome, Mitochondrion |
BioGrid: | 117134. 7 interactions. |
There are currently no product reviews
|